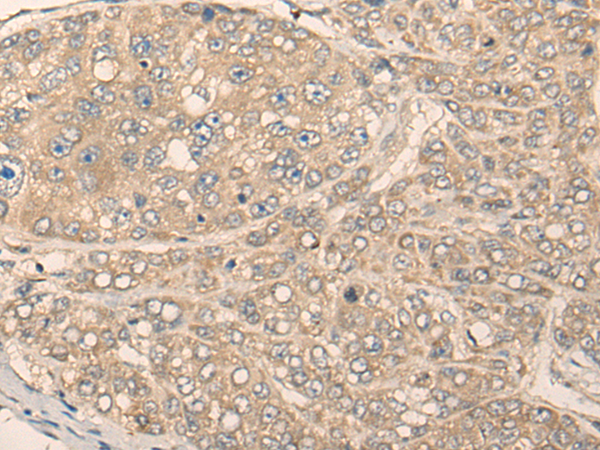

中文名稱 : 兔抗MIIP多克隆抗體
英文名稱 : Anti-MIIP rabbit polyclonal antibody
別 名 : IIP45
儲 存 : 冷凍(-20℃)
抗 原 : MIIP
宿 主 : Rabbit
相關類別 : 一抗
反應種屬 : Human, Mouse, Rat
標 記 物 : Unconjugate
克隆類型 : rabbit polyclonal
技術規(guī)格
|
Background: |
This gene encodes a protein that interacts with the oncogene protein insulin-like growth factor binding protein 2 and may function as an inhibitor of cell migration and invasion. This protein also interacts with the cell division protein 20 and may be involved in regulating mitotic progression. This protein may function as a tumor suppressor by inhibiting the growth or certain cancers. |
|
Applications: |
ELISA, IHC |
|
Name of antibody: |
MIIP |
|
Immunogen: |
Synthetic peptide of human MIIP |
|
Full name: |
migration and invasion inhibitory protein |
|
Synonyms: |
IIP45 |
|
SwissProt: |
Q5JXC2 |
|
ELISA Recommended dilution: |
5000-10000 |
|
IHC positive control: |
Human liver cancer and human esophagus cancer |
|
IHC Recommend dilution: |
25-100 |

購物車
購物車 幫助
幫助
 021-54845833/15800441009
021-54845833/15800441009
